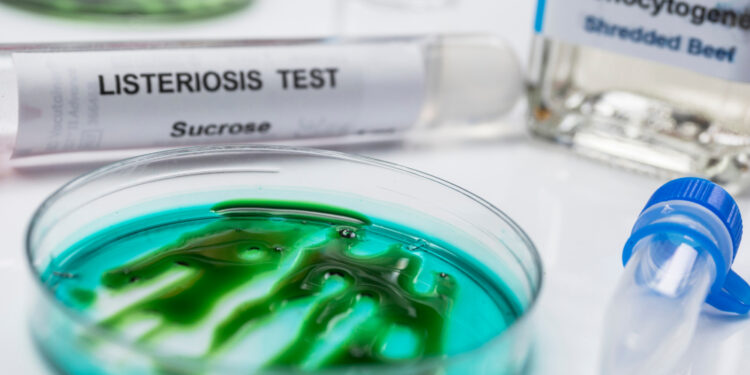
Listeriozė (listerijų sukeliama infekcija): priežastys, simptomai ir gydymas

Listeriozė – tai maisto sukelta infekcija, kurią sukelia bakterijos Listeria monocytogenes. Kasdienėje kalbojeListeriozė (listerijų sukeliama infekcija): priežastys, simptomai ir gydymas ji neretai trumpinama tiesiog į „Listeria“. Ši bakterija dažniausiai plinta per užkrėstą maistą ir gali sukelti įvairaus sunkumo sveikatos sutrikimų – nuo lengvos savijautos pablogėjimo iki rimtų komplikacijų tiems, kurių imuninė sistema silpnesnė, senyvo amžiaus žmonėms bei nėščioms moterims.
- 1.Kaip užsikrečiama listerioze
- 2.Kokie produktai dažniausiai būna užteršti listerijomis?
- 3.Listeriozės simptomai
- 4.Per kiek laiko pasireiškia simptomai?
- 5.Kada listerija kelia didesnį pavojų?
- 6.Kaip diagnozuojama listeriozė?
- 7.Gydymas ir valdymas
- 8.Ar listeriozė užkrečiama žmogui nuo žmogaus?
- 9.Kaip apsisaugoti nuo listeriozės?
- 10.Ligos eiga ir prognozė
Kaip užsikrečiama listerioze
Listeriozės infekcija atsiranda tada, kai suvalgomas ar išgeriamas produktas, užterštas Listeria monocytogenes bakterija. Bakterija gali patekti į žmogaus organizmą per įvairius žalius arba termiškai neapdorotus maisto produktus. Nėščiosioms ši infekcija pavojinga tuo, kad gali būti perduota vaisiui nėštumo ar gimdymo metu, todėl itin svarbu laikytis atsargumo priemonių.
Kokie produktai dažniausiai būna užteršti listerijomis?
- Dešros, šaltai rūkyti mėsos gaminiai, dešrelės
- Mėsos paštetai ir užtepėlės
- Šaltai rūkyta žuvis, pavyzdžiui, lašiša
- Minkšti, brandinti sūriai (Brie, Camembert, queso fresco)
- Nepasterizuoti pieno produktai (pienas, sūris, ledai)
- Nepasterizuotos vaisių sultys, pavyzdžiui, obuolių sidras
- Neplauti arba žali vaisiai ir daržovės, ypač melionai
- Daiginti grūdai ir pupelės
- Žalias sušis
Listeriozės simptomai
Infekcijos požymiai gali būti neryškūs arba labai sunkūs. Dažniau lengvesni simptomai – karščiavimas, galvos skausmas, viduriavimas, pykinimas, vėmimas, raumenų ar sąnarių skausmai, nuovargis, šaltkrėtis. Visgi ne visi užsikrėtusieji jaučia visus šiuos simptomus.
Jei bakterijos plinta už virškinamojo trakto ribų (vadinama invazine listerioze), būklė gali smarkiai pablogėti. Tokiu atveju gali pasireikšti sunkesni simptomai, tokie kaip:
- Sutrikusi pusiausvyra
- Kaklo sustingimas
- Sumišimas
- Traukuliai
Per kiek laiko pasireiškia simptomai?
Po užteršto maisto vartojimo pirmieji listeriozės požymiai gali pasirodyti nuo kelių dienų iki dviejų savaičių. Nėščiosios dažnai jaučia nestiprius arba visai nejaučia simptomų, bet infekcija vis tiek gali būti perduota kūdikiui.
Kada listerija kelia didesnį pavojų?
Nors daugelis žmonių jaučia tik lengvus simptomus, kai kurie asmenys, pavyzdžiui, nėščiosios, vyresni nei 65 metų amžiaus arba žmonės su silpnesne imunine sistema, gali susirgti sunkia ligos forma.
- Nėštumas
- Vyresnis nei 65 metų amžius
- Lėtinės ligos arba vartojami imunitetą silpninantys vaistai
Kokios galimos komplikacijos?
Listeriozė gali sukelti rimtų sveikatos problemų, jei bakterijos išplinta po visą organizmą. Tokios komplikacijos gali būti:
- Širdies (endokarditas), kaulų (osteomielitas) arba pilvo ertmės dangalų (peritonitas) uždegimai
- Smegenų ir nugaros smegenų uždegimas (encefalitas) arba jų dangalų uždegimas (meningitas)
- Persileidimas, negyvas gimdymas, priešlaikinis gimdymas
- Plaučių uždegimas
- Sepsis – sunki uždegiminė reakcija, pažeidžianti organus
- Kraujo užkrėtimas (septikemija), kai bakterijos per kraują išplinta po visą kūną
- Šlapimo takų infekcijos
- Mirtis
Kai kuriems žmonėms, ypač naujagimiams ar tiems, kurių infekcija išplinta į smegenis ar sukelia sepsį, gali likti ilgalaikių pasekmių, tokių kaip protinio vystymosi sulėtėjimas, aklumas, organų pažeidimai, paralyžius ar nuolatiniai traukuliai.
Kaip diagnozuojama listeriozė?
Tiksliai nustatyti listeriozę galima tik atlikus tyrimus – dauguma žmonių dėl lengvų simptomų jų neatlieka. Gydytojas gali įtarti šią infekciją, jei pasireiškė būdingi požymiai ir buvo vartojamas potencialiai užkrėstas maistas.
Diagnozei patvirtinti dažnai atliekami:
- Kraujo tyrimai
- Smegenų ar nugaros smegenų skysčio tyrimai
- Nėščiosioms – vaisiaus vandenų arba placentos audinio tyrimai
- Galvos smegenų vaizdavimo tyrimai (kompiuterinė tomografija ar magnetinis rezonansas) esant neurologiniams simptomams
Gydymas ir valdymas
Daugeliu atvejų, jei simptomai yra lengvi, gydymo gali neprireikti, ypač jei pacientas nėra nėščia ar neturi rimtų rizikos veiksnių. Tačiau sunki listeriozės forma gydoma antibiotikais – dažniausiai skiriami tokie kaip sulfametoksazolas ar ampicilinas. Labai svarbu išgerti visą paskirtą kursą vaistų pagal gydytojo nurodymus, net jei pasijutote geriau anksčiau, nes kitaip infekcija gali sugrįžti.
Kada būtina kreiptis į gydytoją?
- Jei esate nėščia, vyresni nei 65 metų arba jūsų imunitetas silpnesnis ir juntate listeriozės simptomus
- Jei sužinojote, kad neseniai vartotas produktas atšauktas dėl Listeria užteršimo – ypač svarbu nėščiosioms
- Jei kūdikiui pasireiškia listeriozės požymiai
- Jei pavartojus antibiotikų, simptomai nesumažėja per kelias dienas
Taip pat visada pravartu pasikonsultuoti su gydytoju dėl paskirtų vaistų vartojimo ir jų dozavimo.
Ar listeriozė užkrečiama žmogui nuo žmogaus?
Listerijos nuo žmogaus žmogui neskleidžiamos – liga nėra užkrečiama aplinkiniams.
Kaip apsisaugoti nuo listeriozės?
- Rinkitės tik pasterizuotus pieno produktus ir sultis
- Prieš gaminant visada gerai plaukite rankas ir virtuvinius paviršius
- Žalius vaisius bei daržoves plaukite tekančiu vandeniu ir naudokite šepetėlį
- Termiškai apdorokite hotdogus, kiaušinius ir jūros gėrybes iki vidinės 74°C temperatūros
- Nėščiosioms rekomenduojama nevalgyti atvėsintų paštetų ar mėsos užtepėlių iš parduotuvės, o dešreles ar karštus patiekalus prieš valgant gerai pakaitinti
- Laiku išvalykite šaldytuvo išbėgusių maisto skysčių liekanas, ypač mėsos sultis
Be to, Listeria bakterija žūsta pakankamai aukštoje temperatūroje, todėl gerai verdant ar kepant maistą rizika užsikrėsti smarkiai sumažėja.
Ligos eiga ir prognozė
Žmonėms su stipria imunine sistema bei tiems, kurie nėra nėščia, listeriozės simptomai paprastai praeina per kelias dienas savaime. Tačiau, jei priklausote rizikos grupei arba simptomai stiprūs, būtina nedelsti ir kreiptis į gydytoją, nes sunki ligos forma gali baigtis mirtimi.
Pravers ilsėtis ir vartoti pakankamai skysčių, vengti alkoholio ir kofeino, nes šios medžiagos gali dar labiau paskatinti viduriavimą. Kai kurie nereceptiniai preparatai gali padėti palengvinti simptomus, tačiau prieš duodami jų vaikams, būtinai pasitarkite su gydytoju.